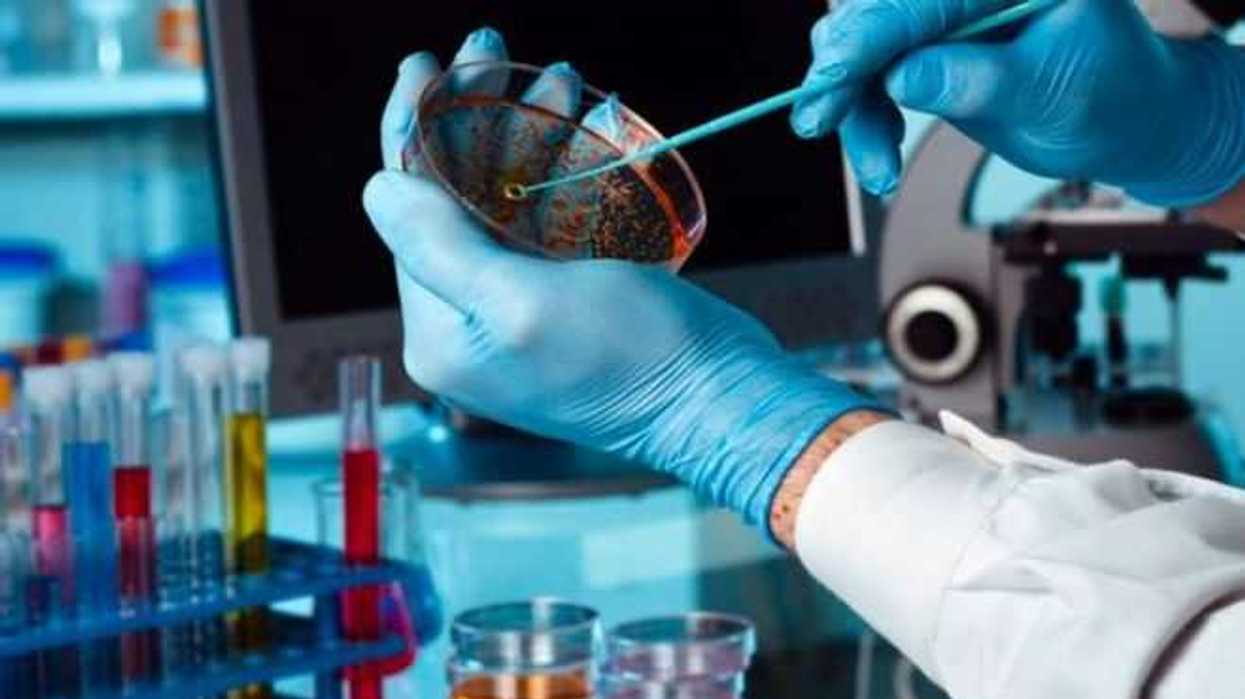
biotecnologia-reduce-poblacion-de-insectos

México, 30 Abr (Notimex).- A través de métodos biotecnológicos, investigadores universitarios trabajan en el desarrollo de técnicas que permitirían controlar la población de uno de los insectos que transmiten el dengue, zika y chikungunya y chagas.
En estos proyectos participan académicos de las universidades Autónoma de Aguscalientes (UAA) y Autónoma de Nuevo León (UANL), así como del Centro de Biotecnología Genómica de Tamaulipas.
En un comunicado de la UAA, se informó que debido al uso indiscriminado de insecticidas a nivel mundial, diversos insectos que transmiten organismos infecciosos se han vuelto más resistentes, lo cual ha obligado a los científicos a buscar alternativas.
El proyecto de esta universidad consiste en el uso de hongos entomopatógenos, los cuales son letales en insectos, para infectar especímenes machos del mosquito Aedes aegypti, también conocido como mosquito de la fiebre amarilla, transmisor de enfermedades como el dengue, zika y chikungunya.
El objetivo es que, al momento del apareamiento o intento de cópula, se diseminen esporas del hongo en las hembras de esta especie, lo que la llevaría a la muerte o en lo sucesivo huevos infértiles e insectos que no serán viables para su reproducción, logrando un balance de la plaga.
Alberto Margarito García Munguía, profesor investigador del Centro de Ciencias Agropecuarias y coordinador de esta investigación, explicó que en los próximos meses se llevarán a cabo las pruebas de esta novedosa técnica, liberando mosquitos infectados con el hongo a nivel de laboratorio, para posteriormente evaluar la efectividad.
De acuerdo al experto y según los resultados obtenidos hasta ahora, se llegaría a la liberación de los insectos en el entorno para lograr reducir la posibilidad de contraer algunos de los padecimientos que se transmiten a las personas.
Efraín Islas Ojeda, también profesor investigador del Centro de Ciencias Agropecuarias, está trabajando en la aplicación de la técnica mencionada a otras especies, como la chinche besucona, que transmite el parásito Trypanosoma cruzi, causante de la enfermedad de chagas.
El especialista explicó que ese insecto cuenta con una alta presencia en Aguascalientes, y aunque no se han presentado casos de afectaciones que hayan sido contraídas propiamente en la entidad, se deben emprender acciones para el control de su población, pues los efectos a la salud son graves.
En este sentido, señaló que la enfermedad de chagas causa lesiones en niños, las cuales van desde inflamación en la zona donde ocurrió la picadura a través de la cual se transmitió el Trypanosoma cruzi, hasta pérdida de la vista.
Además, agregó, los tratamientos ante este padecimiento suelen ser complicados y largos, por lo que la actuación de los investigadores de la UAA busca mejorar las condiciones de vida de la sociedad ante estas problemáticas latentes.
En estos proyectos participan académicos de las universidades Autónoma de Aguscalientes (UAA) y Autónoma de Nuevo León (UANL), así como del Centro de Biotecnología Genómica de Tamaulipas.
En un comunicado de la UAA, se informó que debido al uso indiscriminado de insecticidas a nivel mundial, diversos insectos que transmiten organismos infecciosos se han vuelto más resistentes, lo cual ha obligado a los científicos a buscar alternativas.
El proyecto de esta universidad consiste en el uso de hongos entomopatógenos, los cuales son letales en insectos, para infectar especímenes machos del mosquito Aedes aegypti, también conocido como mosquito de la fiebre amarilla, transmisor de enfermedades como el dengue, zika y chikungunya.
El objetivo es que, al momento del apareamiento o intento de cópula, se diseminen esporas del hongo en las hembras de esta especie, lo que la llevaría a la muerte o en lo sucesivo huevos infértiles e insectos que no serán viables para su reproducción, logrando un balance de la plaga.
Alberto Margarito García Munguía, profesor investigador del Centro de Ciencias Agropecuarias y coordinador de esta investigación, explicó que en los próximos meses se llevarán a cabo las pruebas de esta novedosa técnica, liberando mosquitos infectados con el hongo a nivel de laboratorio, para posteriormente evaluar la efectividad.
De acuerdo al experto y según los resultados obtenidos hasta ahora, se llegaría a la liberación de los insectos en el entorno para lograr reducir la posibilidad de contraer algunos de los padecimientos que se transmiten a las personas.
Efraín Islas Ojeda, también profesor investigador del Centro de Ciencias Agropecuarias, está trabajando en la aplicación de la técnica mencionada a otras especies, como la chinche besucona, que transmite el parásito Trypanosoma cruzi, causante de la enfermedad de chagas.
El especialista explicó que ese insecto cuenta con una alta presencia en Aguascalientes, y aunque no se han presentado casos de afectaciones que hayan sido contraídas propiamente en la entidad, se deben emprender acciones para el control de su población, pues los efectos a la salud son graves.
En este sentido, señaló que la enfermedad de chagas causa lesiones en niños, las cuales van desde inflamación en la zona donde ocurrió la picadura a través de la cual se transmitió el Trypanosoma cruzi, hasta pérdida de la vista.
Además, agregó, los tratamientos ante este padecimiento suelen ser complicados y largos, por lo que la actuación de los investigadores de la UAA busca mejorar las condiciones de vida de la sociedad ante estas problemáticas latentes.

Lo que todo principiante necesita saber antes de invertir en criptomonedas. 






La tecnología QLED utiliza puntos cuánticos para mayor brillo y fidelidad de color, con ventaja clara en ambientes con luz natural. Shutterstock
La tecnología QLED utiliza puntos cuánticos para mayor brillo y fidelidad de color, con ventaja clara en ambientes con luz natural. Shutterstock 
La Luna adoptó un tono rojizo intenso durante los 58 minutos de totalidad del eclipse lunar total de este 3 de marzo. Infografía Rotativo. 
La protección de datos y la atención en español figuran entre los factores más valorados por los usuarios al seleccionar plataformas verificadas.
La protección de datos y la atención en español figuran entre los factores más valorados por los usuarios al seleccionar plataformas verificadas.